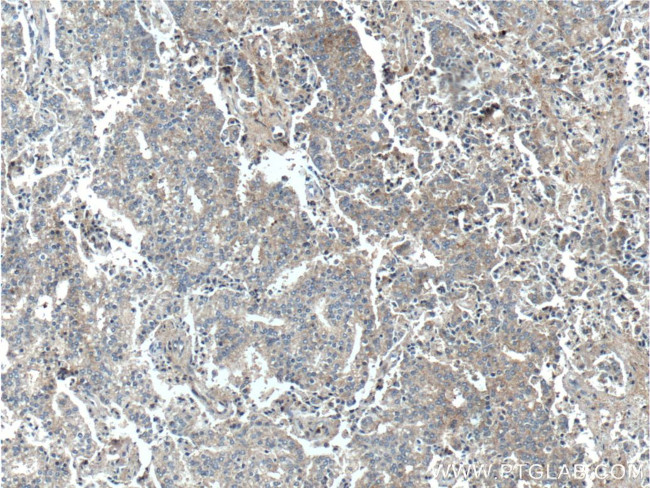
TSLP Antibody in Immunohistochemistry (Paraffin) (IHC (P))

Search
Proteintech
TSLP Polyclonal Antibody
{{$productOrderCtrl.translations['antibody.pdp.commerceCard.promotion.promotions']}}
{{$productOrderCtrl.translations['antibody.pdp.commerceCard.promotion.viewpromo']}}
{{$productOrderCtrl.translations['antibody.pdp.commerceCard.promotion.promocode']}}: {{promo.promoCode}} {{promo.promoTitle}} {{promo.promoDescription}}. {{$productOrderCtrl.translations['antibody.pdp.commerceCard.promotion.learnmore']}}
产品信息
13778-1-AP
种属反应
已发表种属
宿主/亚型
分类
类型
抗原
偶联物
形式
浓度
规格
纯化类型
保存液
内含物
保存条件
运输条件
产品详细信息
Immunogen sequence: MKTKAALAI WCPGYSETQI NATQAMKKRR KRKVTTNKCL EQVSQLQGLW RRFNRPLLKQ Q (1-60 aa encoded by BC016720)
靶标信息
TSLP is a 159 amino acid four helix-bundle hemopoietic cytokine that signals through a heterodimeric receptor complex consisting of the human TSLP receptor and the IL-7R alpha-chain. It impacts myeloid cells and induces the release of T cell-attracting chemokines from monocytes, enhances the maturation of CD11c (+) dendritic cells, naive CD4 (+), and CD8 (+) T cells into proallergic effectors, and primes dendritic cells to produce large amounts of IL-12 after CD40 ligand stimulation. TSLP influences the regulation of the positive selection of regulatory T cells and maintenance of peripheral CD4 (+) T cell homeostasis. It induces allergic inflammation by directly activating mast cells and may be involved in the pathophysiology of inflammatory arthritis. It is expressed in heart, liver and prostate.
仅用于科研。不用于诊断过程。未经明确授权不得转售。
生物信息学
蛋白别名: cytokine; short-chain four-helical bundle cytokine; Thymic stromal lymphopoietin
基因别名: TSLP
UniProt ID: (Human) Q969D9
Entrez Gene ID: (Human) 85480